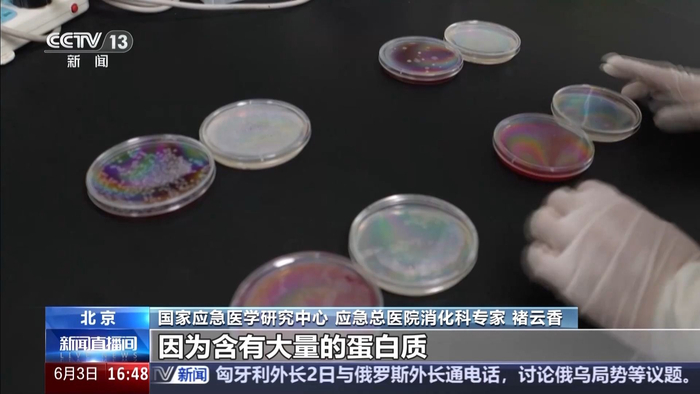

来源:央视新闻客户端
本周华北黄淮等地高温将有所发展,局地最高气温将达39℃。室外气温攀升,车内密闭环境下,气温最高能飙升到六七十摄氏度。那些看似平常的车内物品,在高温的炙烤下,却可能摇身一变,成为“危险品”。
不久前,浙江嘉兴平湖市的沈先生准备从单位驾车外出,刚打开车门却发现车内正冒着黑烟。后经消防部门初步调查,起火原因为车内的USB数据线接口故障发热引燃了座椅导致事故的发生。

后经过核实,沈先生车辆的车顶、中控台以及副驾驶座椅被部分烧损。
无独有偶,5月15日,北京大兴一辆私家车前挡风玻璃处突然冒出了浓烟,小区微型消防站队员和一名外卖小哥第一时间使用灭火器处置将火扑灭。经调查确认,此次起火是车主遗留在车内的充电宝在高温环境下发生“热失控”所致。
高温遇明火 瓶装水也可助燃
消防部门提示,爱车不能当作储藏室。夏天天气炎热,经暴晒后车内温度很高,像矿泉水瓶、老花镜、灌装喷雾以及电池类产品都可能引发火灾。为了让大家更加直观地了解这些隐患,消防员进行了模拟试验。
炎热的夏季,阳光照进车内,导致车内的温度急剧升高。我们随手放置在车内的物品,可能会有不小的风险。有的车主将车内除臭剂放在储物盒里。但是,这小小的除臭剂,在高温下却暗藏风险。

江苏省扬州市消防救援支队消防员 姚相宇:像我们常用的除臭剂里边除了含有除臭剂、杀菌剂之外,很多会有无水乙醇,包括把这些药剂驱动出来的气体,很多气罐它会选择用LPG,也就是我们所说的液化石油气,是属于易燃可燃的气体。

消防员进行了模拟试验,在车外用明火模拟高温环境下引燃除臭剂的情况,可以看到遇到明火后瞬间被引燃。消防员提示,这些气体如果扩散到一个有限的空间里面,很容易形成爆炸性混合气体,发生爆燃的情况,所以高温环境下一定不要将这类物品留在车内。那炎热的高温下,我们在车内饮水再正常不过了,瓶装水随手放置在车内,又会发生什么样的情况呢?

试验表明,夏日汽车在密闭环境下,车内温度可达到六七十摄氏度。光线经过瓶装水折射聚焦后,照射面上的温度可能高达120℃甚至更高,如果旁边此时正好放置有充电宝、香水等物品,则有可能引发意外。

山东航空学院理学院物理学博士 刘慧:生活中瓶装水通常是圆柱形的,这种结构符合凸透镜的特征,光线进入瓶装水内部介质时会改变传播方向发生折射。光源发出来的光经过凸透镜,会向中心位置汇聚,能量也就随之汇聚,从而使温度升高。除了瓶装水外,生活中用到的老花镜也是典型的凸透镜。
消防部门提醒,像锂电池、打火机、香水、罐装喷雾等物品,都会因为车内高温而引起自燃或者爆炸,下车后一定要随手带离,切忌遗留在车内。
专家:车内高温加速细菌滋生 隔夜饮料勿饮用
高温下在车内安全,我们不仅关注消防安全,健康也很重要。很多人习惯在车内放几瓶矿泉水和冰镇饮料,渴了来上几口,没喝完就随手放在车内。那么经过高温暴晒后,这些瓶装水和饮料,还能喝吗?是否有健康风险呢?
记者和检验人员分别将未开封和开封饮用过的矿泉水和红豆薏米水饮料分组标记,放置在车内前挡风玻璃下,经过72小时高温放置后,送往实验室进行真菌细菌检测实验。检验人员将四组样品标记后,同时放置特定的环境下,进行真菌细菌的检测实验。

总台央视记者 王晨:经过实验,我们发现未开封的纯净水和红豆薏米水是没有检测出来细菌和真菌的,而开封的纯净水和红豆薏米水,这些检测结果都呈阳性。
专家提醒,开封过的饮品,长时间放置在高温的车内,再次饮用会有健康风险。
国家应急医学研究中心 应急总医院消化科专家 褚云香:开封之后,因为接触口腔之后口腔中的细菌可能会进入到饮料中。如果经过高温暴晒,这种风险会明显增加,随着时间延长,细菌会增长得越来越多。像红豆薏米水,因为含有大量的蛋白质,可能会给细菌提供更多的繁殖条件,变质的时间会更短。像这种尽量都不建议隔夜饮用。
责任编辑:孙源熙




